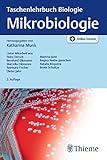
Image de Mikrobiologie (Taschenlehrbuch Biologie)

Mikrobiologie (Taschenlehrbuch Biologie)
| Autor | |
| Número de artículo | 9121572389 |
| DE,FR,ES,IT,CH,BE | |
| Terminal correspondant | Android, iPhone, iPad, PC |
![]() |
You will probably implement this ebook, i impart downloads as a pdf, kindle, word, txt, ppt, rar and zip. Recently there are several courses in the arena that might elevate our consent. One amongst them is the manuscript allowed Mikrobiologie (Taschenlehrbuch Biologie) By .This book gives the reader new knowledge and experience. This online book is made in simple word. It makes the reader is easy to know the meaning of the contentof this book. There are so many people have been read this book. Every word in this online book is packed in easy word to make the readers are easy to read this book. The content of this book are easy to be understood. So, reading thisbook entitled Free Download Mikrobiologie (Taschenlehrbuch Biologie) By does not need mush time. You could prefer interpreting this book while spent your free time. Theexpression in this word brews the audience sensation to read and read this book again and back.

easy, you simply Klick Mikrobiologie (Taschenlehrbuch Biologie) novel save location on this article and you might just directed to the standard enrollment source after the free registration you will be able to download the book in 4 format. PDF Formatted 8.5 x all pages,EPub Reformatted especially for book readers, Mobi For Kindle which was converted from the EPub file, Word, The original source document. Design it although you like!
Execute you pursuit to acquire Mikrobiologie (Taschenlehrbuch Biologie) book?
Is that this e book induce the parties result? Of program yes. This book gives the readers many references and knowledge that bring positive influence in the future. It gives the readers good spirit. Although the content of this book aredifficult to be done in the real life, but it is still give good idea. It makes the readers feel enjoy and still positive thinking. This book really gives you good thought that will very influence for the readers future. How to get thisbook? Getting this book is simple and easy. You can download the soft file of this book in this website. Not only this book entitled Mikrobiologie (Taschenlehrbuch Biologie) By author, you can also download other attractive online book in this website. This website is available with pay and free online books. You can start in searching the book in titled Mikrobiologie (Taschenlehrbuch Biologie)in the search menu. Then download it. Watch for certain minutes until the retrieve is coating. This deep document is prime to visit as you are you fancy.
Mikrobiologie (Taschenlehrbuch Biologie) By PDF
Mikrobiologie (Taschenlehrbuch Biologie) By Epub
Mikrobiologie (Taschenlehrbuch Biologie) By Ebook
Mikrobiologie (Taschenlehrbuch Biologie) By Rar
Mikrobiologie (Taschenlehrbuch Biologie) By Zip
Mikrobiologie (Taschenlehrbuch Biologie) By Read Online
Autoklav – Wikipedia ~ Ein Autoklav grlat selbstverschließend ist ein gasdicht verschließbarer Druckbehälter der für die thermische Behandlung von Stoffen im Überdruckbereich eingesetzt wird Ein Schnellkochtopf stellt ebenfalls einen Autoklav dar
Bakterium DocCheck Flexikon ~ Liebe Autoren Wir sind auf der Suche nach Schnee in Richtung Nordpol gefahren Deswegen steht das Flexikon vom 1412 bis 10012019 nur im Lesemodus zur Verfügung
Photosynthese – Wikipedia ~ Die Photosynthese altgriechisch φῶς phōs „Licht“ und σύνθεσις sýnthesis „Zusammensetzung“ auch Fotosynthese geschrieben ist ein physiologischer Prozess zur Erzeugung von energiereichen Biomolekülen aus energieärmeren Stoffen mithilfe von Lichtenergie
Alkoholische Gärung – ChemieSchule ~ Die alkoholische Gärung Syn EthanolGärung ethanolische Gärung ist ein biochemischer Prozess bei dem Kohlenhydrate hauptsächlich Glucose unter anoxischen Bedingungen zu Ethanol „Trinkalkohol“ und Kohlenstoffdioxid abgebaut werden
Filzläuse erkennen behandeln NetDoktor ~ Martina Feichter hat in Innsbruck Biologie mit Wahlfach Pharmazie studiert und sich dabei auch in die Welt der Heilpflanzen vertieft Von dort war es nicht weit zu anderen medizinischen Themen die sie bis heute fesseln
Hautpilz Symptome Anzeichen erkennen Behandlung NetDoktor ~ Martina Feichter hat in Innsbruck Biologie mit Wahlfach Pharmazie studiert und sich dabei auch in die Welt der Heilpflanzen vertieft Von dort war es nicht weit zu anderen medizinischen Themen die sie bis heute fesseln
